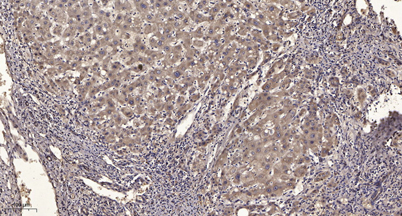

$148.00/50µL $248.00/100µL
| 50 µL | $148.00 |
| 100 µL | $248.00 |
| Product name: | SgK269 rabbit pAb |
| Reactivity: | Human;Rat;Mouse; |
| Alternative Names: | PEAK1; KIAA2002; Pseudopodium-enriched atypical kinase 1; Sugen kinase 269; Tyrosine-protein kinase SgK269 |
| Source: | Rabbit |
| Dilutions: | WB 1:500-2000;IHC-p 1:50-300 |
| Immunogen: | The antiserum was produced against synthesized peptide derived from human SGK269. AA range:111-160 |
| Storage: | -20°C/1 year |
| Clonality: | Polyclonal |
| Isotype: | IgG |
| Concentration: | 1 mg/ml |
| Observed Band: | 195kD |
| GeneID: | 79834 |
| Human Swiss-Prot No: | Q9H792 |
| Cellular localization: | Cytoplasm, cytoskeleton . Cell junction, focal adhesion . Colocalizes with F-actin in serum-rich medium (PubMed:20534451). Actin colocalization is reduced during serum starvation (PubMed:20534451). . |
| Background: | This gene encodes a non-receptor tyrosine kinase that is a member of the new kinase family three (NFK3) family. In migrating cells, the encoded protein is associated with the actin cytoskeleton and focal adhesions and promotes developing focal adhesion elongation. This protein may play a role in the regulation of cell migration, proliferation and cancer metastasis. [provided by RefSeq, Mar 2014], |